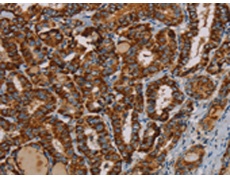
一抗

中文名稱: 兔抗MRPL12多克隆抗體
英文名稱: Anti-MRPL12 rabbit polyclonal antibody
別 名: 5c5-2; L12mt; MRPL7; RPML12; MRPL7/L12; MRP-L31/34
相關類別: 一抗
儲 存: 冷凍(-20℃)
宿 主: Rabbit
抗 原: MRPL12
反應種屬: Human, Mouse
標 記 物: Unconjugate
克隆類型: rabbit polyclonal
技術規(guī)格
|
Background: |
Mammalian mitochondrial ribosomal proteins are encoded by nuclear genes and help in protein synthesis within the mitochondrion. Mitochondrial ribosomes (mitoribosomes) consist of a small 28S subunit and a large 39S subunit. They have an estimated 75% protein to rRNA composition compared to prokaryotic ribosomes, where this ratio is reversed. Another difference between mammalian mitoribosomes and prokaryotic ribosomes is that the latter contain a 5S rRNA. Among different species, the proteins comprising the mitoribosome differ greatly in sequence, and sometimes in biochemical properties, which prevents easy recognition by sequence homology. |
|
Applications: |
ELISA, WB, IHC |
|
Name of antibody: |
MRPL12 |
|
Immunogen: |
Fusion protein of human MRPL12 |
|
Full name: |
mitochondrial ribosomal protein L12 |
|
Synonyms: |
5c5-2; L12mt; MRPL7; RPML12; MRPL7/L12; MRP-L31/34 |
|
SwissProt: |
P52815 |
|
ELISA Recommended dilution: |
2000-5000 |
|
IHC positive control: |
Human thyroid cancer and human cervical cancer |
|
IHC Recommend dilution: |
50-200 |
|
WB Predicted band size: |
21 kDa |
|
WB Positive control: |
293T cells |
|
WB Recommended dilution: |
500-2000 |


 購物車
購物車 幫助
幫助
 021-54845833/15800441009
021-54845833/15800441009